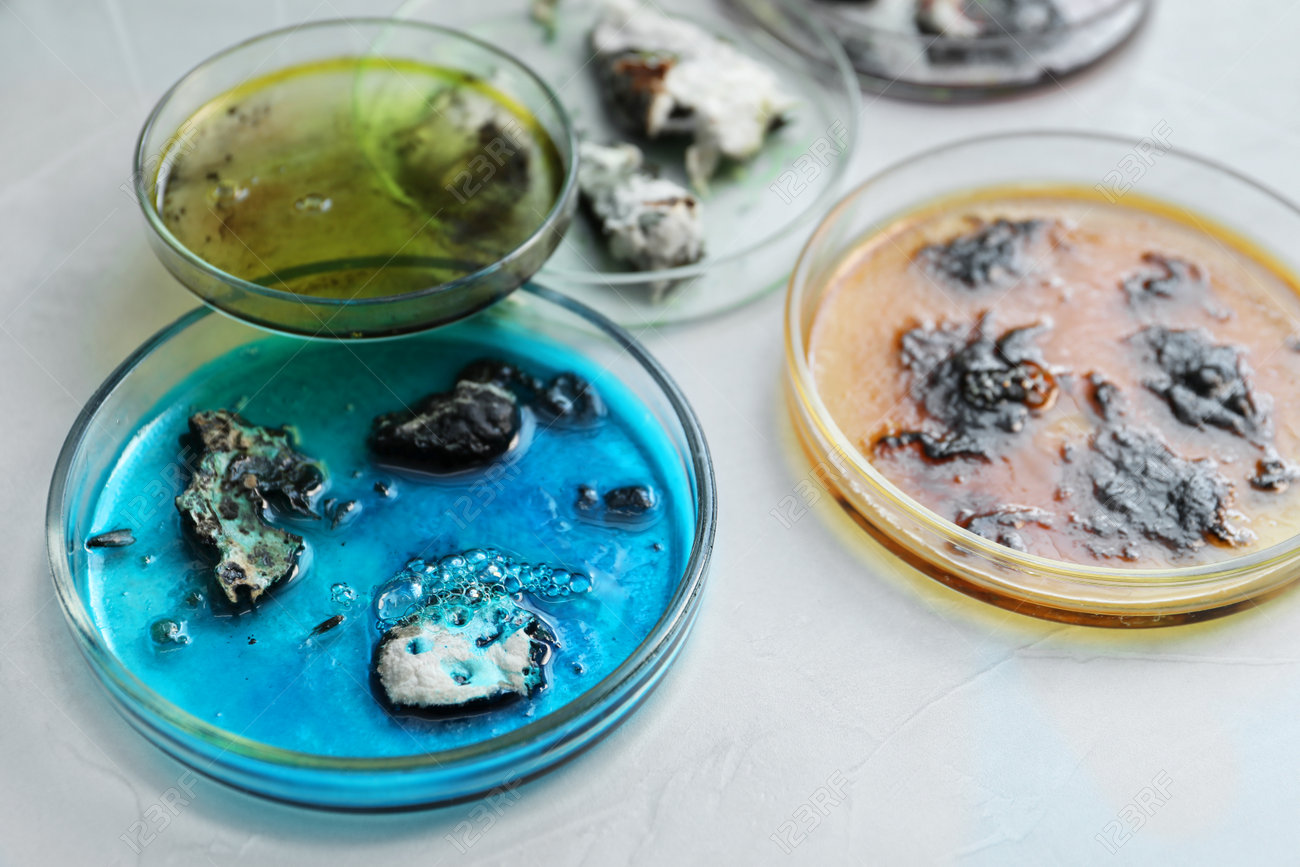
etiam-dictum-ipsum-a-felis

Download
Close
Автор:
id:
Ключевые слова:
analysis, background, bacteria, bacteriology, bacterium, biochemistry, biological, biology, biotechnology, chemical, chemistry, clinic, closeup, culture, disease, dishes, equipment, experiment, glass, glassware, health, industry, infectious, lab, laboratory, light, medical, medicine, microbial, microbiology, microorganism, mold, mycobacterium, object, petri, reagent, research, researching, samples, science, scientific, study, table, test, virus,





